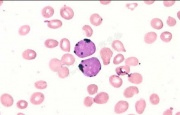

文件列表
来自医学百科
本特殊页面展示所有上传的文件。
| 日期 | 名称 | 缩略图 | 尺寸 | 用户 | 说明 | 版本 |
|---|---|---|---|---|---|---|
| 2014年1月17日 (五) 18:28 | Glwd4zdg.jpg (文件) | 18 KB | Admin | 1 | ||
| 2014年1月17日 (五) 18:28 | Bkdik.jpg (文件) |  |
6 KB | Admin | 1 | |
| 2014年1月17日 (五) 18:28 | Bkgvr.jpg (文件) |  |
6 KB | Admin | 1 | |
| 2014年1月17日 (五) 18:28 | Glxeph5v.gif (文件) |  |
18 KB | Admin | 1 | |
| 2014年1月17日 (五) 18:28 | Bk2cj.jpg (文件) |  |
7 KB | Admin | 1 | |
| 2014年1月17日 (五) 18:27 | Bkmsp.jpg (文件) |  |
12 KB | Admin | 1 | |
| 2014年1月17日 (五) 18:27 | Glmfkg9u.jpg (文件) |  |
16 KB | Admin | 1 | |
| 2014年1月17日 (五) 18:27 | Bkm4b.jpg (文件) |  |
42 KB | Admin | 1 | |
| 2014年1月17日 (五) 18:27 | Bka1v.jpg (文件) |  |
3 KB | Admin | 1 | |
| 2014年1月17日 (五) 18:27 | Gl99r60v.jpg (文件) |  |
16 KB | Admin | 1 | |
| 2014年1月17日 (五) 18:27 | Bk33l.jpg (文件) |  |
4 KB | Admin | 1 | |
| 2014年1月17日 (五) 18:27 | Gl0uj3s7.jpg (文件) |  |
12 KB | Admin | 1 | |
| 2014年1月17日 (五) 18:26 | Glnkwmxp.jpg (文件) |  |
31 KB | Admin | 1 | |
| 2014年1月17日 (五) 18:26 | Bkfoh.jpg (文件) |  |
72 KB | Admin | 1 | |
| 2014年1月17日 (五) 18:26 | Bke4l.jpg (文件) |  |
4 KB | Admin | 1 | |
| 2014年1月17日 (五) 18:26 | Goo9vlga.jpg (文件) |  |
5 KB | Admin | 1 | |
| 2014年1月17日 (五) 18:26 | Guwbezni.jpg (文件) |  |
7 KB | Admin | 1 | |
| 2014年1月17日 (五) 18:26 | Bkfmu.jpg (文件) |  |
88 KB | Admin | 1 | |
| 2014年1月17日 (五) 18:26 | Bkl72.jpg (文件) |  |
81 KB | Admin | 1 | |
| 2014年1月17日 (五) 18:25 | Glxcnx32.jpg (文件) |  |
30 KB | Admin | 1 | |
| 2014年1月17日 (五) 18:25 | Bk3u1.jpg (文件) |  |
6 KB | Admin | 1 | |
| 2014年1月17日 (五) 18:25 | Bkdoh.jpg (文件) |  |
8 KB | Admin | 1 | |
| 2014年1月17日 (五) 18:25 | Gt864nvx.jpg (文件) |  |
6 KB | Admin | 1 | |
| 2014年1月17日 (五) 18:25 | Bk8ct.jpg (文件) |  |
42 KB | Admin | 1 | |
| 2014年1月17日 (五) 18:25 | Bked1.jpg (文件) |  |
7 KB | Admin | 1 | |
| 2014年1月17日 (五) 18:25 | Bk5e3.jpg (文件) |  |
227 KB | Admin | 1 | |
| 2014年1月17日 (五) 18:25 | Bk67z.jpg (文件) |  |
54 KB | Admin | 1 | |
| 2014年1月17日 (五) 18:25 | Bkkqp.jpg (文件) |  |
143 KB | Admin | 1 | |
| 2014年1月17日 (五) 18:24 | Gl3rd40f.jpg (文件) |  |
8 KB | Admin | 1 | |
| 2014年1月17日 (五) 18:24 | Bkb2o.jpg (文件) |  |
3 KB | Admin | 1 | |
| 2014年1月17日 (五) 18:24 | Bkgif.jpg (文件) | |
15 KB | Admin | 1 | |
| 2014年1月17日 (五) 18:24 | Gxqegclr.jpg (文件) |  |
15 KB | Admin | 1 | |
| 2014年1月17日 (五) 18:24 | Bkgx2.jpg (文件) |  |
155 KB | Admin | 1 | |
| 2014年1月17日 (五) 18:24 | Bkoxz.jpg (文件) |  |
11 KB | Admin | 1 | |
| 2014年1月17日 (五) 18:23 | Bkef4.jpg (文件) |  |
10 KB | Admin | 1 | |
| 2014年1月17日 (五) 18:23 | Bka9k.jpg (文件) |  |
48 KB | Admin | 1 | |
| 2014年1月17日 (五) 18:23 | Bk6jj.jpg (文件) |  |
5 KB | Admin | 1 | |
| 2014年1月17日 (五) 18:23 | Bkab9.jpg (文件) |  |
14 KB | Admin | 1 | |
| 2014年1月17日 (五) 18:23 | Bk0t0.jpg (文件) |  |
92 KB | Admin | 1 | |
| 2014年1月17日 (五) 18:23 | Bk2j1.jpg (文件) |  |
35 KB | Admin | 1 | |
| 2014年1月17日 (五) 18:23 | Bk0ei.jpg (文件) |  |
14 KB | Admin | 1 | |
| 2014年1月17日 (五) 18:23 | Bk39r.jpg (文件) |  |
57 KB | Admin | 1 | |
| 2014年1月17日 (五) 18:23 | Gkrw989i.jpg (文件) |  |
13 KB | Admin | 1 | |
| 2014年1月17日 (五) 18:23 | Bkift.jpg (文件) |  |
27 KB | Admin | 1 | |
| 2014年1月17日 (五) 18:23 | Bkdpa.jpg (文件) |  |
144 KB | Admin | 1 | |
| 2014年1月17日 (五) 18:22 | Glnjp8vh.jpg (文件) |  |
58 KB | Admin | 1 | |
| 2014年1月17日 (五) 18:22 | Gmoe9a55.jpg (文件) |  |
4 KB | Admin | 1 | |
| 2014年1月17日 (五) 18:22 | Bkoq0.jpg (文件) |  |
7 KB | Admin | 1 | |
| 2014年1月17日 (五) 18:22 | Bkhom.jpg (文件) |  |
35 KB | Admin | 1 | |
| 2014年1月17日 (五) 18:22 | Gunu873s.jpg (文件) |  |
28 KB | Admin | 1 |